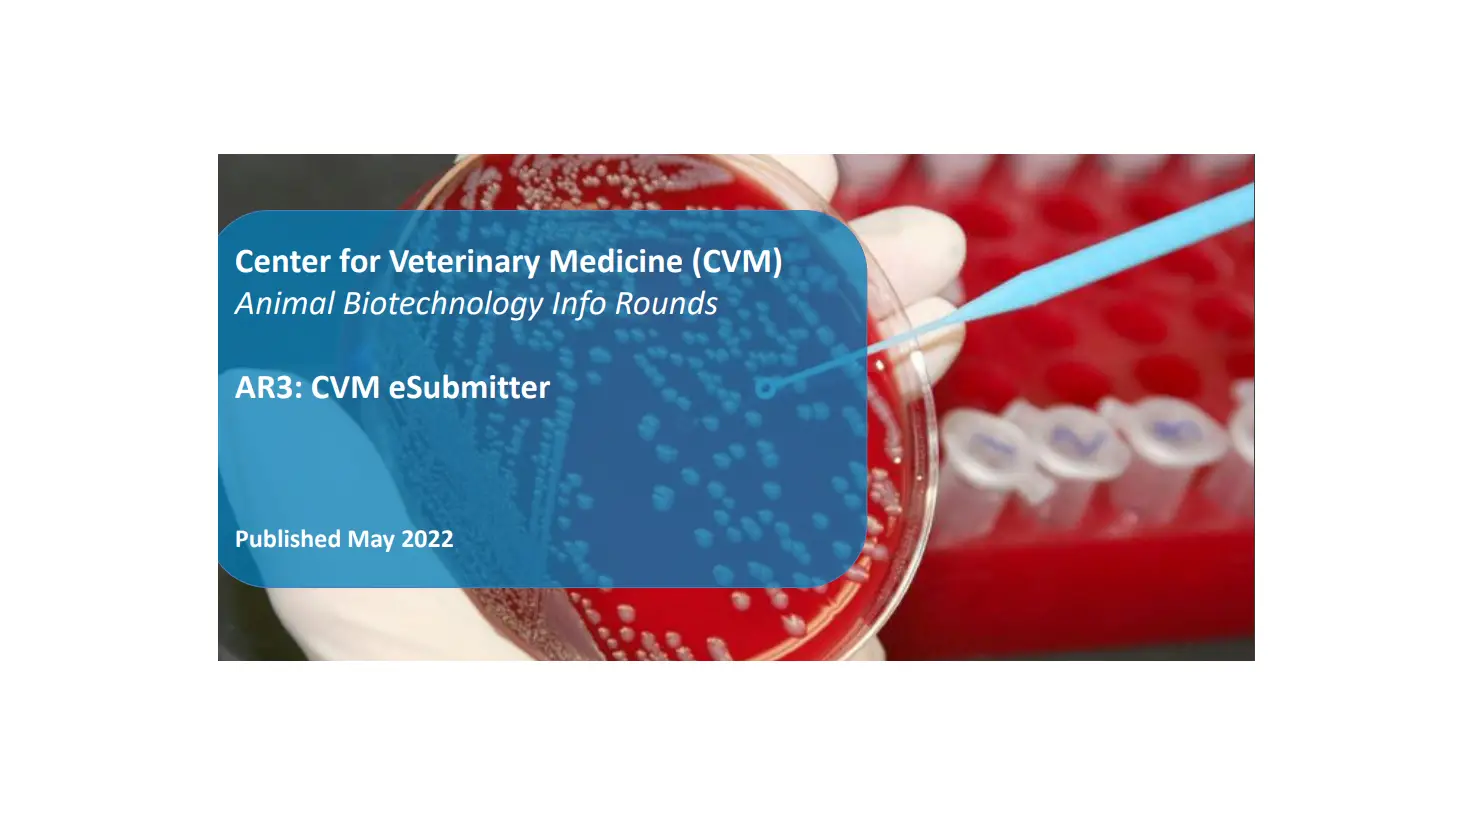
Fda Cvm Esubmitter Data Book User Guide Fda Cvm Esubmitter Data Book User Guide

lenalidomide REMS Risk Evaluation and Mitigation Strategy

This guide provides you important information about:
- The risks of lenalidomide
- Birth defects (deformed babies) or death of an unborn baby
- Low white blood cells (neutropenia) and low platelets (thrombocytopenia)
- Blood clots in your arteries (heart attacks and strokes), veins (deep vein thrombosis), and lungs (pulmonary embolism). To reduce this increased risk, most people who take lenalidomide will also take a blood thinner medicine
- Lenalidomide REMS
- What females who can get pregnant need to know
- Birth control options
- What females who can not get pregnant need to know
- What males need to know
- What females who can get pregnant need to know
Risks of Lenalidomide
Lenalidomide is similar to the medicine thalidomide (THALOMID®). Thalidomide can cause severe life-threatening birth defects. If lenalidomide is used during pregnancy, it can cause birth defects or death to unborn babies. Lenalidomide must not be used by pregnant females and females who are able to get pregnant. Females who are able to get pregnant must avoid pregnancy while taking lenalidomide.
Lenalidomide causes low white blood cells (neutropenia) and low platelets (thrombocytopenia) in most patients.
Lenalidomide causes a higher chance for blood clots in your arteries (heart attacks and strokes), veins (deep vein thrombosis), and lungs (pulmonary embolism). To reduce this increased risk, most people who take lenalidomide will also take a blood thinner medicine.
These are not all of the serious risks of lenalidomide. Please read the Medication Guide for lenalidomide for more information about all of the risks with lenalidomide use. The Medication Guide can be found at www.LenalidomideREMS.com.
What is Lenalidomide REMS?
To avoid serious risks to unborn babies, lenalidomide is only available under a restricted distribution program called “Lenalidomide Risk Evaluation and Mitigation Strategy (REMS)”. Only certified prescribers can prescribe lenalidomide and only certified pharmacies can dispense lenalidomide.
In order to receive lenalidomide, patients must be enrolled in Lenalidomide REMS and agree to follow the requirements.
For more information about lenalidomide and Lenalidomide REMS, please visit www.LenalidomideREMS.com, or call Lenalidomide REMS toll-free at 1-888-423-5436.
How to Receive Your First Prescription of Lenalidomide
For Females
Counseling
Your healthcare provider will counsel you on:
- Why and how you and your partner should prevent pregnancy
- Using two effective birth control methods (at least one highly effective method and one effective method)
- Not sharing lenalidomide
- Not donating blood
- Not to open, break, chew, or crush lenalidomide capsules or handle them any more than needed
Pregnancy Test #1
If you can get pregnant, you must take an initial pregnancy test within 10-14 days before getting a lenalidomide prescription
Pregnancy Test #2
If you can get pregnant, you must take a second pregnancy test within 24 hours before getting a lenalidomide prescription
Enrollment
You and your healthcare provider will then complete and submit the Lenalidomide REMS Patient-Physician Agreement Form
Complete Mandatory Confidential Survey
You and your healthcare provider will each complete a survey. Visit www.CelgeneRiskManagement.com, access the REMS Patient Companion app, or call 1-888-423-5436 and press 1 to take your survey
Prescription
Your healthcare provider will send your prescription to a certified pharmacy
Pharmacy Call
The certified pharmacy will call you and will provide counseling on the serious risks and safety rules of Lenalidomide REMS. They will also discuss the delivery of lenalidomide to you
Receive Lenalidomide
Lenalidomide will be shipped to the address you provide. Someone must sign for this shipment
For each of your following prescriptions, pregnancy tests will be required depending on your ability to get pregnant. For specific pregnancy test requirements, please refer to page 10 of this guide. For full detailed information about Lenalidomide REMS requirements, please visit www.LenalidomideREMS.com.
For Males
Counseling
Your healthcare provider will counsel you on:
- Why and how you and your partner should prevent pregnancy
- Required condom use
- Not sharing lenalidomide
- Not donating blood or sperm
- Not to open, break, chew, or crush lenalidomide capsules or handle them any more than needed
Enrollment
You and your healthcare provider will then complete and submit the Lenalidomide REMS Patient-Physician Agreement Form
Complete Mandatory Confidential Survey
You will not have to take a survey for your first prescription, but will have to for the following ones. Visit www.CelgeneRiskManagement.com, access the REMS Patient Companion app, or call 1-888-423-5436 and press 1 to take your survey
Prescription
Your healthcare provider will send your prescription to a certified pharmacy
Pharmacy Call
The certified pharmacy will contact you to provide counseling on the serious risks and safe-use conditions of lenalidomide before you receive your prescription. They will also coordinate delivery of lenalidomide to you
Receive Lenalidomide
Lenalidomide will be shipped to the address you provide. Someone must sign for this shipment
For each of your following prescriptions, you will need to follow a similar process. For full detailed information about Lenalidomide REMS requirements, please visit www.LenalidomideREMS.com.
What do All Patients Need to Know About Lenalidomide REMS?
General Guidelines
- This medicine is only for you. Do not share it with anyone even if they have symptoms like yours. It may harm them and can cause birth defects
- Lenalidomide must be kept out of the reach of children
- Do not open or crush lenalidomide capsules.
If powder in the capsule comes in contact with your skin, wash the area with soap and water - Keep lenalidomide in a cool, dry place
- Do not donate blood while you are taking lenalidomide, during breaks (dose interruptions), and for 4 weeks after stopping lenalidomide
- Return any unused lenalidomide capsules to Lenalidomide REMS by calling 1-888-423-5436 or to your lenalidomide prescriber, or to the pharmacy that dispensed the lenalidomide to you
What do females who can get pregnant need to know about Lenalidomide REMS?
Before Taking Lenalidomide
- You must sign the Lenalidomide REMS
Patient-Physician Agreement Form that says you understand that lenalidomide should not be used during pregnancy, and that you agree not to become pregnant while taking lenalidomide - If there is any chance that you can get pregnant, you must agree to use at the same time at least 1 highly effective method and at least 1 additional effective method of birth control every time you have sex with a male starting at least 4 weeks before taking lenalidomide
- Your healthcare provider must give you a pregnancy test 10 to 14 days before you receive your first prescription for lenalidomide, and again within 24 hours before you receive your first prescription for lenalidomide. If you are pregnant, you cannot take lenalidomide
- You will have pregnancy tests before starting lenalidomide and while taking lenalidomide, even if you agree not to have sex with a male
- Before your healthcare provider can write your prescription for lenalidomide, you must take part in a mandatory confidential survey. The survey will make sure that you understand and can follow information designed to prevent serious risks to unborn babies
- Before dispensing lenalidomide, your Lenalidomide REMS certified pharmacy will contact you to discuss treatment
- Your healthcare provider will talk with you about your birth control options
- Choose at least 1 highly effective method and at least 1 additional effective method of birth control. Talk to your healthcare provider about the following acceptable birth control methods. See below.
Effective Methods of Birth Control Used at the Same TimeHighly effective birth control methods
Intrauterine device (IUD)Hormonal methods (birth control pills, hormonal patches, injections, vaginal rings, or implants)
Additional effective birth control methods Male latex or synthetic condom
Tubal ligation (having your + Diaphragm tubes tied) Partner’s vasectomy (tying of the tubes to prevent the passing of sperm) Cervical cap - Use the 2 methods of birth control at the same time
- Remember: You must use at the same time at least 1 highly effective method and at least 1 additional effective method of birth control every time you have sex with a male. However, your healthcare provider may recommend that you use 2 different methods instead for medical reasons
- Talk to your healthcare provider to make sure that other medicines or dietary supplements you are taking do not interfere with your hormonal birth control methods
- Remember, not having sex at all times is the only method of birth control that is 100% effective
- Unacceptable methods of birth control
- Progesterone-only “mini-pills”
- IUD Progesterone T
- Female condoms
- Natural family planning (rhythm method) or breastfeeding
- Fertility awareness
- Withdrawal
- Cervical shield*
- Take pregnancy tests
- You must have a pregnancy test performed by your healthcare provider 10 to 14 days before receiving your first prescription for lenalidomide and again within 24 hours before receiving your first prescription for lenalidomide. Both pregnancy tests must have a negative result
* A cervical shield should not be confused with a cervical cap, which is an effective secondary form of contraception.
While Taking Lenalidomide
- If you are able to get pregnant, you must continue (including during breaks [dose interruptions]) to use at the same time at least 1 highly effective method and at least 1 additional effective method of birth control every time you have sex with a male
- Remember, not having sex at all times is the only method of birth control that is 100% effective
- You must talk to your healthcare provider before changing any birth control methods you have already agreed to use
- You will have a pregnancy test performed by your healthcare provider:
- Every week during the first 4 weeks of treatment, then
- Every 4 weeks if your menstrual cycles are regular, or
- Every 2 weeks if your cycles are irregular
- If you miss your period or have unusual menstrual bleeding, or
- If your medication is not dispensed within 7 days of taking the pregnancy test
- If you had sex with a male without using birth control or if you think your birth control has failed, stop taking lenalidomide immediately and call your healthcare provider right away. Your healthcare provider will discuss your options, which may include emergency birth control. Do not wait until your next appointment to tell your healthcare provider if you miss your menstrual period or if you think you may be pregnant
- If you get pregnant, or think you may be pregnant, you must immediately stop taking lenalidomide. Contact your healthcare provider immediately to discuss your pregnancy. If you do not have an obstetrician (OB/GYN), your healthcare provider will refer you to one for care and counseling
- You must not breastfeed while you are taking lenalidomide
- In order to continue receiving lenalidomide, you must take part in a mandatory confidential survey every month. You must also continue to discuss your treatment with your Lenalidomide REMS healthcare provider. To take the survey, please visit www.CelgeneRiskManagement.com, access the REMS Patient Companion app, or call Lenalidomide REMS at 1-888-423-5436
Attention Females Who Can Get Pregnant:
Tear out this letter to take with you to your next medical appointment that discusses your birth control options.
This letter will help you and your healthcare provider understand what types of birth control options are the best for you.
Dear Healthcare Provider,
Your patient is being treated with lenalidomide. Due to its structural similarity to thalidomide, a known teratogen, lenalidomide is only available under a restricted distribution program approved by the Food and Drug Administration. This program is called Lenalidomide REMS (Risk Evaluation and Mitigation Strategy).
The goals of Lenalidomide REMS are:
- To prevent the risk of embryo-fetal exposure to lenalidomide.
- To inform prescribers, patients, and pharmacists on the serious risks and safe-use conditions for lenalidomide.
To enroll in Lenalidomide REMS, your patient, with the knowledge of the healthcare provider who prescribed lenalidomide, agreed to follow the program’s contraception requirements while on lenalidomide therapy. Unless she completely abstains from sexual intercourse with a male partner, she is required to use at the same time at least one highly effective birth control method and at least one additional effective method.
The 2 effective contraceptive methods must be started at least 4 weeks before lenalidomide therapy, during therapy (including dose interruptions), and for at least 4 weeks following discontinuation of therapy. Please refer to the table below of the acceptable forms of contraception to help facilitate the discussion on contraception.
Effective Methods of Birth Control Used at the Same Time

Unacceptable Forms of Contraception:
progesterone-only “mini-pills,” IUD Progesterone T, female condoms, natural family planning (rhythm method) or breastfeeding, fertility awareness, withdrawal, cervical shield (a cervical shield should not be confused with a cervical cap, which is an effective secondary form of contraception).
Remind all patients that not having any sexual intercourse at all times is the only birth control method that is 100% effective.
Patients should be counseled that concomitant use of certain prescription drugs and/or dietary supplements can decrease the effects of hormonal contraception. If hormonal or IUD contraception is medically contraindicated, 2 other contraceptive methods may be used simultaneously during periods of concomitant use and for 4 weeks after.
Instruct patient to immediately stop taking lenalidomide and contact her doctor if she becomes pregnant while taking this drug, if she misses her menstrual period or experiences unusual menstrual bleeding, if she stops taking birth control or if she thinks FOR ANY REASON that she may be pregnant. Advise patient that if her doctor is not available she can call Lenalidomide REMS at 1-888-423-5436.
There are other risks associated with lenalidomide treatment as described in the Prescribing Information.
For full Prescribing Information, including Boxed Warnings, or details about Lenalidomide REMS, please visit www.LenalidomideREMS.com.
You may contact Lenalidomide REMS at 1-888-423-5436 if you have any questions about the information contained in this letter or the safe and effective use of lenalidomide.
Sincerely,
The Lenalidomide REMS Sponsors
After You Have Stopped Taking Lenalidomide
- You must continue to use at the same time at least 1 highly effective method and at least 1 additional effective method of birth control every time you have sex with a male:
- For at least 4 weeks after stopping lenalidomide, or
- Do not have any sex with a male for 4 weeks after stopping lenalidomide
What do Females Who can not Get Pregnant Need to Know About Lenalidomide REMS?
Before Taking Lenalidomide
- You must sign the Lenalidomide REMS Patient-Physician Agreement Form that says you are currently not pregnant and are not able to get pregnant. This means that:
- You have been in natural menopause for at least 2 years, or
- You have had both ovaries and/or uterus removed
- For females who have not started their period (menstruation) and are under the age of 18, a parent or legal guardian must sign the Lenalidomide REMS Patient-Physician Agreement Form that says the patient is not pregnant, is not able to get pregnant, and/or will not be having sex with a male for at least 4 weeks before starting lenalidomide
- Before your healthcare provider can write your prescription for lenalidomide, you must take part in a mandatory confidential survey. The survey will make sure that you understand and can follow information designed to prevent serious risks to unborn babies
- Before dispensing lenalidomide, your Lenalidomide REMS certified pharmacy will contact you to discuss treatment
While Taking Lenalidomide
- In order to continue receiving lenalidomide, you must take part in a mandatory confidential survey every six months. You must also continue to discuss your treatment with your Lenalidomide REMS healthcare provider. To take the survey, please visit www.CelgeneRiskManagement.com, access the REMS Patient Companion app, or call Lenalidomide REMS at 1-888-423-5436
What do Males Need to Know About Lenalidomide REMS?
- You must use a latex or synthetic condom, every time you have sex with a female who is able to get pregnant, even if you have had a successful vasectomy (tying of the tubes to prevent the passing of sperm)
Before Taking Lenalidomide
- You must sign the Lenalidomide REMS Patient-Physician Agreement Form. You must agree that while taking lenalidomide you will use a latex or synthetic condom every time you have sex with a female who is pregnant or who is able to get pregnant, even if you have had a successful vasectomy (tying of the tubes to prevent the passing of sperm)
- Before dispensing lenalidomide, your Lenalidomide REMS certified pharmacy will contact you to discuss treatment
While Taking Lenalidomide
- You must use a latex or synthetic condom every time (including during breaks [dose interruptions]) you have sex with a female who is pregnant or who is able to get pregnant, even if you have had a successful vasectomy (tying of the tubes to prevent the passing of sperm)
- Remember, not having sex at all times is the only method of birth control that is 100% effective
- You must tell your healthcare provider right away if you had sex with a female without using a latex or synthetic condom, if you think for any reason that your partner may be pregnant, or if your partner is pregnant. If your healthcare provider is not available, call Lenalidomide REMS at 1-888-423-5436
- You must not donate sperm while taking lenalidomide (including during breaks [dose interruptions])
- In order to continue receiving lenalidomide, you must take part in a mandatory confidential survey every month. You must also continue to discuss your treatment with your Lenalidomide REMS healthcare provider. To take the survey, please visit www.CelgeneRiskManagement.com, access the REMS Patient Companion app, or call Lenalidomide REMS at 1-888-423-5436
After You Have Stopped Taking Lenalidomide
- For 4 weeks after receiving your last dose of lenalidomide, you must use a latex or synthetic condom every time you have sex with a female who is pregnant or who is able to get pregnant, even if you have had a successful vasectomy (tying of the tubes to prevent the passing of sperm)
- You must not donate sperm for 4 weeks after stopping lenalidomide
Mandatory Confidential Patient Surveys
As a patient who is enrolled in Lenalidomide REMS, you must complete a brief mandatory confidential survey as outlined below:
Adult females who can get pregnant
- Initial survey before first prescription
- Monthly
Adult females who can not get pregnant
- Initial survey before first prescription
- Every six months
Female children
- Initial survey before first prescription
- Monthly
Males
- No initial survey
- Monthly
Mandatory Confidential Survey Process
- When your healthcare provider tells you to take the survey, go to the patient Mandatory Confidential Survey section of www.CelgeneRiskManagement.com, the REMS Patient Companion app, or call Lenalidomide REMS at 1-888-423-5436
- Be prepared with your patient identification number
- After completing your survey, your healthcare provider will also complete a survey. Your healthcare provider will then receive authorization to write your prescription
- The prescription will be sent to a Lenalidomide REMS certified pharmacy. The Lenalidomide REMS certified pharmacy will contact you to discuss your lenalidomide therapy. You will not receive your medication until you speak with the Lenalidomide REMS certified pharmacy
Warning to Patients Taking Lenalidomide
Attention Females
Do not take lenalidomide if you are pregnant, if you are breastfeeding, or if you are able to get pregnant and are not using at the same time at least 1 highly effective method and at least 1 additional effective method of birth control every time you have sex with a male.
Attention Males
You must use a latex or synthetic condom every time you have sex with a female who is pregnant or who is able to get pregnant, even if you have had a successful vasectomy (tying of the tubes to prevent the passing of sperm).
You must not donate sperm while taking lenalidomide, during breaks (dose interruptions), and for 4 weeks after stopping lenalidomide.
Attention All Patients
You must not donate blood while taking lenalidomide, during breaks (dose interruptions), and for 4 weeks after stopping lenalidomide.
This medicine is only for you. Do not share it with anyone even if they have symptoms like yours. It may harm them and can cause birth defects.
Lenalidomide must be kept out of the reach of children. Return any unused lenalidomide capsules for disposal to Lenalidomide REMS by calling 1-888-423-5436, or to your lenalidomide prescriber, or to the pharmacy that dispensed the lenalidomide to you.
You may require regular blood tests during lenalidomide treatment. Consult with your healthcare provider.
For more information about lenalidomide and Lenalidomide REMS, please visit www.LenalidomideREMS.com, or call Lenalidomide REMS at 1-888-423-5436.
Lenalidomide REMS
86 Morris Ave
Summit, NJ 07901
Lenalidomide is only available under a restricted distribution program, Lenalidomide REMS.
Please read the Medication Guide for lenalidomide for more information regarding risks with lenalidomide use and see the relevant full Prescribing Information, including Boxed WARNINGS at www.LenalidomideREMS.com.